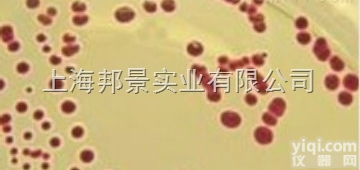
<em>果糖</em>（<em>脑膜炎</em><em>奈瑟</em>氏菌专用）价格

果糖(脑膜炎奈瑟氏菌专用) 生化管
- 产地:国产|进口
- 供应商:上海广锐生物科技有限公司
- 供应商报价:面议
- 标签:果糖(脑膜炎奈瑟氏菌专用) 生化管,-1,上海广锐生物科技有限公司
| 品牌 | 自营品牌 | 货号 | 培养基 |
|---|---|---|---|
| 规格 | 支 | 供货周期 | 现货 |
| 主要用途 | 果糖(脑膜炎奈瑟氏菌专用) 生化管 |
果糖(脑膜炎奈瑟氏菌专用) 生化管 公司产品有干粉培养基、细菌微量生化管、配套试剂、药敏纸片、一次性成品培养基及试剂原料等。
1.规格:20支、9种*10支、11种*10支、16种*10支、13种*10支、20支/盒、9cm平板
2.库存均有现货,果糖(脑膜炎奈瑟氏菌专用) 可现做。
3.以库存产品价格为准。
4.出库前复检保证质量。
广锐生物不断开拓与创新,致力于“做好的培养基”,竭诚为广大国内外客户提供优质果糖(脑膜炎奈瑟氏菌专用) 生化管
微生物干粉培养基:有细菌总数,大肠杆菌,金黄色葡萄球菌,沙门氏菌,霉菌酵母菌,李斯特菌等所有细菌的普通培养基和显色培养基。
一次性成品培养基的产品有:血琼脂平板、营养琼脂平板、伊红美蓝平板、SS平板、麦康凯平板、TSA平板,沙宝罗葡萄糖琼脂平板,显色培养基平板;
一次性管装培养基:乳糖胆盐管装培养基/10ML、硫乙醇酸盐管装培养基/50ML、改良马丁管装培养基/50ML等。
微生物生化管:大肠杆菌科生化管,沙门氏菌生化管等。
果糖(脑膜炎奈瑟氏菌专用) 同一批库存其他产品:
1268798其他试剂|木犀草苷
大鼠脂多糖结合蛋白(LBP)ELISA试剂盒
对甲基苯丁酮99%100ml
人5羟色胺(5-HT)含量试剂盒
PoFAineNoradrenaline,NEELISAKit
二十八酸AR100MG
HumanSolubleClusterofdifferentiation30ligand,sCD30LELISAKit
邻乙酰水杨酰氯96%100g
辅酶Ⅰ98%500g
2,4,6-三氯苯胺≥99.5%100g
72962-43-7芸苔素内酯,油菜素内酯98对照品
HumanLegionellaantibodyIgG,LPAb-IgGELISAKit
芸香柚皮苷分析标准品,≥98%20mg
鸡N-乙酰-β-D-氨基葡萄糖苷酶(NAG)含量试剂盒
伽升沃D≥98对照品
BP-984≥99.0%100g
邻氟氯苄≥99.0%25g
肉汤培养基A培养基
乙酰胺脒盐酸盐≥99%100g
1892-57-5其他试剂|1-(3-二甲基胺丙基)-3-乙基碳二亚胺
无水硫化钠AR500g
528-58-5其他试剂|氯化花青素
rabbitoxidizedlowdensitylipoprotein,OxLDLELISAKit
大鼠胰岛素样生长因子结合蛋白1(IGFBP-1)ELISA试剂盒
RatBonemorphogeneticprotein2,BMP-2ELISAKit
邻香兰素99%25g
人巨噬细胞替代激活相关化学因子1(AmAC-1)含量试剂盒
5-氯-2-甲基苯甲酸≥98%500g
MouseVascularEndothelialcellGrowthFactorC,VEGF-CELISAkit
葡萄球菌增菌肉汤培养基
85026-55-7络缌HPLC≥98对照品
副溶血性弧菌生化鉴定管
(2-HAP)2'-羟基苯乙酮98.50%100ml
氟氧头孢药敏纸片
亚S酸钠AR25g
Fmoc-O-叔丁基-L-酪氨酸>98.5%25g
Mouseanti-cardiolipinantibodyIgM,ACA-IgMELISAKit
桂酸异戊酯98%500g
2139626其他试剂|溴化钾
乙基三苯基醋酸膦70%甲醇溶液100g